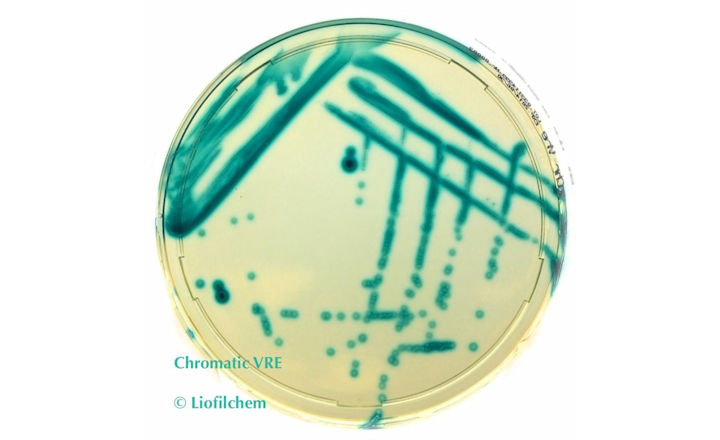
Chromatic VRE: Chromogenic Medium for Screening Vancomycin Resistant Enterococci

An ancient proverb says, "Take care of the Earth, and the Earth will take care of you."
At Liofilchem, we are integrated into our territory, respect it, and protect it with all the resources we have available, from our corporate social sustainability policy to our manufacturing infrastructures.
The Liofilchem production plants are entirely covered by photovoltaic panels and use energy exclusively from renewable sources. Our products are manufactured with zero impact on CO2.
For many years, we have been committed to constantly reducing the plastic packaging materials, weight, and volume of our products. Our suppliers are also selected based on their environmental impact.
Visit the Liofilchem website to learn more about the company or connect directly using the Request Information button below.